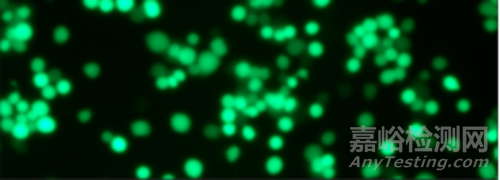

您當(dāng)前的位置:檢測(cè)資訊 > 實(shí)驗(yàn)管理
嘉峪檢測(cè)網(wǎng) 2025-04-10 08:45
1. 實(shí)驗(yàn)概述
細(xì)胞共培養(yǎng)技術(shù)常常被用于探究細(xì)胞間相互作用、疾病模型構(gòu)建、藥物研發(fā)等方面,例如細(xì)胞共培養(yǎng)體系能夠模擬體內(nèi)復(fù)雜的細(xì)胞微環(huán)境,通過(guò)顯微鏡可以直觀觀察不同類型細(xì)胞在共培養(yǎng)時(shí)的行為變化,如細(xì)胞遷移、黏附、分化等,深入了解細(xì)胞間的信號(hào)傳導(dǎo)機(jī)制。下面介紹用顯微鏡觀察細(xì)胞共培養(yǎng)時(shí)常見(jiàn)的問(wèn)題和一些經(jīng)驗(yàn)分享。
2. 經(jīng)驗(yàn)分享
2.1 實(shí)驗(yàn)操作
2.1.1 細(xì)胞接種與培養(yǎng)
細(xì)胞比例
根據(jù)實(shí)驗(yàn)?zāi)康暮图?xì)胞特性確定合適的共培養(yǎng)細(xì)胞比例。比如在研究腫瘤細(xì)胞與免疫細(xì)胞相互作用時(shí),可能需要按照不同的比例將腫瘤細(xì)胞和免疫細(xì)胞進(jìn)行接種,一般可先從1:1、1:2、2:1等比例嘗試,通過(guò)預(yù)實(shí)驗(yàn)確定最佳比例。
接種密度
要保證細(xì)胞在培養(yǎng)過(guò)程中有足夠的生長(zhǎng)空間和營(yíng)養(yǎng)物質(zhì),同時(shí)避免細(xì)胞過(guò)于稀疏或密集影響觀察效果。例如對(duì)于大多數(shù)細(xì)胞,12孔板的接種密度應(yīng)為:5×104~105/cm2個(gè)細(xì)胞。
培養(yǎng)條件優(yōu)化
不同細(xì)胞對(duì)培養(yǎng)條件要求不同,需摸索出適合共培養(yǎng)細(xì)胞的最佳培養(yǎng)條件。如一些細(xì)胞需要5% CO?,而另一些可能需要更高或更低的濃度;培養(yǎng)溫度一般為37℃,但有些特殊細(xì)胞可能需要微調(diào)。
2.1.2 顯微鏡選擇與使用
顯微鏡類型
根據(jù)觀察需求選擇合適的顯微鏡。相差顯微鏡適合觀察活細(xì)胞的形態(tài)和結(jié)構(gòu);熒光顯微鏡(徠卡Leica)可用于觀察細(xì)胞內(nèi)特定熒光標(biāo)記的蛋白、核酸等;共聚焦顯微鏡(ZEISS蔡司)則能實(shí)現(xiàn)對(duì)細(xì)胞的三維成像,更清晰地觀察細(xì)胞內(nèi)部結(jié)構(gòu)和細(xì)胞間的相互作用。
參數(shù)設(shè)置
調(diào)整合適的光照強(qiáng)度、對(duì)比度、焦距等參數(shù)。對(duì)于較厚的細(xì)胞共培養(yǎng)樣本,可適當(dāng)降低光照強(qiáng)度,避免過(guò)度曝光;通過(guò)調(diào)整對(duì)比度使細(xì)胞結(jié)構(gòu)更清晰;使用微調(diào)旋鈕精確聚焦,以獲得清晰的細(xì)胞圖像。
圖像采集
選擇合適的相機(jī)和采集軟件,設(shè)置合適的采集參數(shù),如分辨率、曝光時(shí)間等。一般來(lái)說(shuō),高分辨率的圖像有助于觀察細(xì)胞的細(xì)節(jié),但文件大小也會(huì)相應(yīng)增加。曝光時(shí)間要根據(jù)細(xì)胞的熒光強(qiáng)度或?qū)Ρ榷冗M(jìn)行調(diào)整,避免圖像過(guò)亮或過(guò)暗。
2.2常見(jiàn)問(wèn)題解析
2.2.1細(xì)胞生長(zhǎng)狀態(tài)不佳
原因:可能是培養(yǎng)基成分不合適、血清質(zhì)量差、培養(yǎng)條件不滿足細(xì)胞需求或細(xì)胞本身狀態(tài)不佳等。
解決方法:更換合適的培養(yǎng)基和血清,嚴(yán)格控制培養(yǎng)條件,如溫度、CO?濃度等;對(duì)細(xì)胞進(jìn)行復(fù)蘇、傳代等操作時(shí),要確保操作規(guī)范,避免細(xì)胞受到損傷。
2.2.2 細(xì)胞混雜或污染
原因:細(xì)胞接種過(guò)程中操作不規(guī)范,如未嚴(yán)格遵守?zé)o菌操作原則,導(dǎo)致細(xì)菌、真菌或其他細(xì)胞污染;或者細(xì)胞株本身不純。
解決方法:接種細(xì)胞時(shí)要在超凈工作臺(tái)內(nèi)進(jìn)行,嚴(yán)格消毒雙手和實(shí)驗(yàn)器材;定期對(duì)細(xì)胞進(jìn)行支原體等檢測(cè),一旦發(fā)現(xiàn)污染,及時(shí)丟棄受污染的細(xì)胞,重新復(fù)蘇或購(gòu)買新的細(xì)胞株。
2.2.3 觀察到的細(xì)胞形態(tài)異常
原因:可能是細(xì)胞受到外界因素刺激,如藥物處理、培養(yǎng)環(huán)境改變等;也可能是細(xì)胞處于不同的生長(zhǎng)階段或發(fā)生了病變。
解決方法:分析細(xì)胞形態(tài)異常是否與實(shí)驗(yàn)處理有關(guān),若與藥物處理有關(guān),可調(diào)整藥物濃度或處理時(shí)間;同時(shí),與正常細(xì)胞形態(tài)進(jìn)行對(duì)比,判斷細(xì)胞是否發(fā)生病變或分化。例如BV2細(xì)胞、RAW264.7細(xì)胞等在正常狀態(tài)下均呈現(xiàn)較小的細(xì)胞體,呈圓形或橢圓形,若受到外界環(huán)境的刺激例如細(xì)菌或真菌污染,均可長(zhǎng)出觸角。
2.2.4 熒光信號(hào)弱或背景高
原因:熒光標(biāo)記物的濃度過(guò)低、熒光淬滅、細(xì)胞固定或透化處理不當(dāng)、抗體非特異性結(jié)合等都可能導(dǎo)致熒光信號(hào)弱或背景高。

熒光淬滅,信號(hào)弱,背景高
熒光強(qiáng)度過(guò)高,續(xù)需調(diào)低曝光度
解決方法:優(yōu)化熒光標(biāo)記物的濃度,避免熒光標(biāo)記物長(zhǎng)時(shí)間暴露在光下導(dǎo)致淬滅;嚴(yán)格按照細(xì)胞固定和透化的操作步驟進(jìn)行處理;選擇特異性高的抗體,并進(jìn)行預(yù)實(shí)驗(yàn)確定最佳抗體濃度。

來(lái)源:實(shí)驗(yàn)老司機(jī)